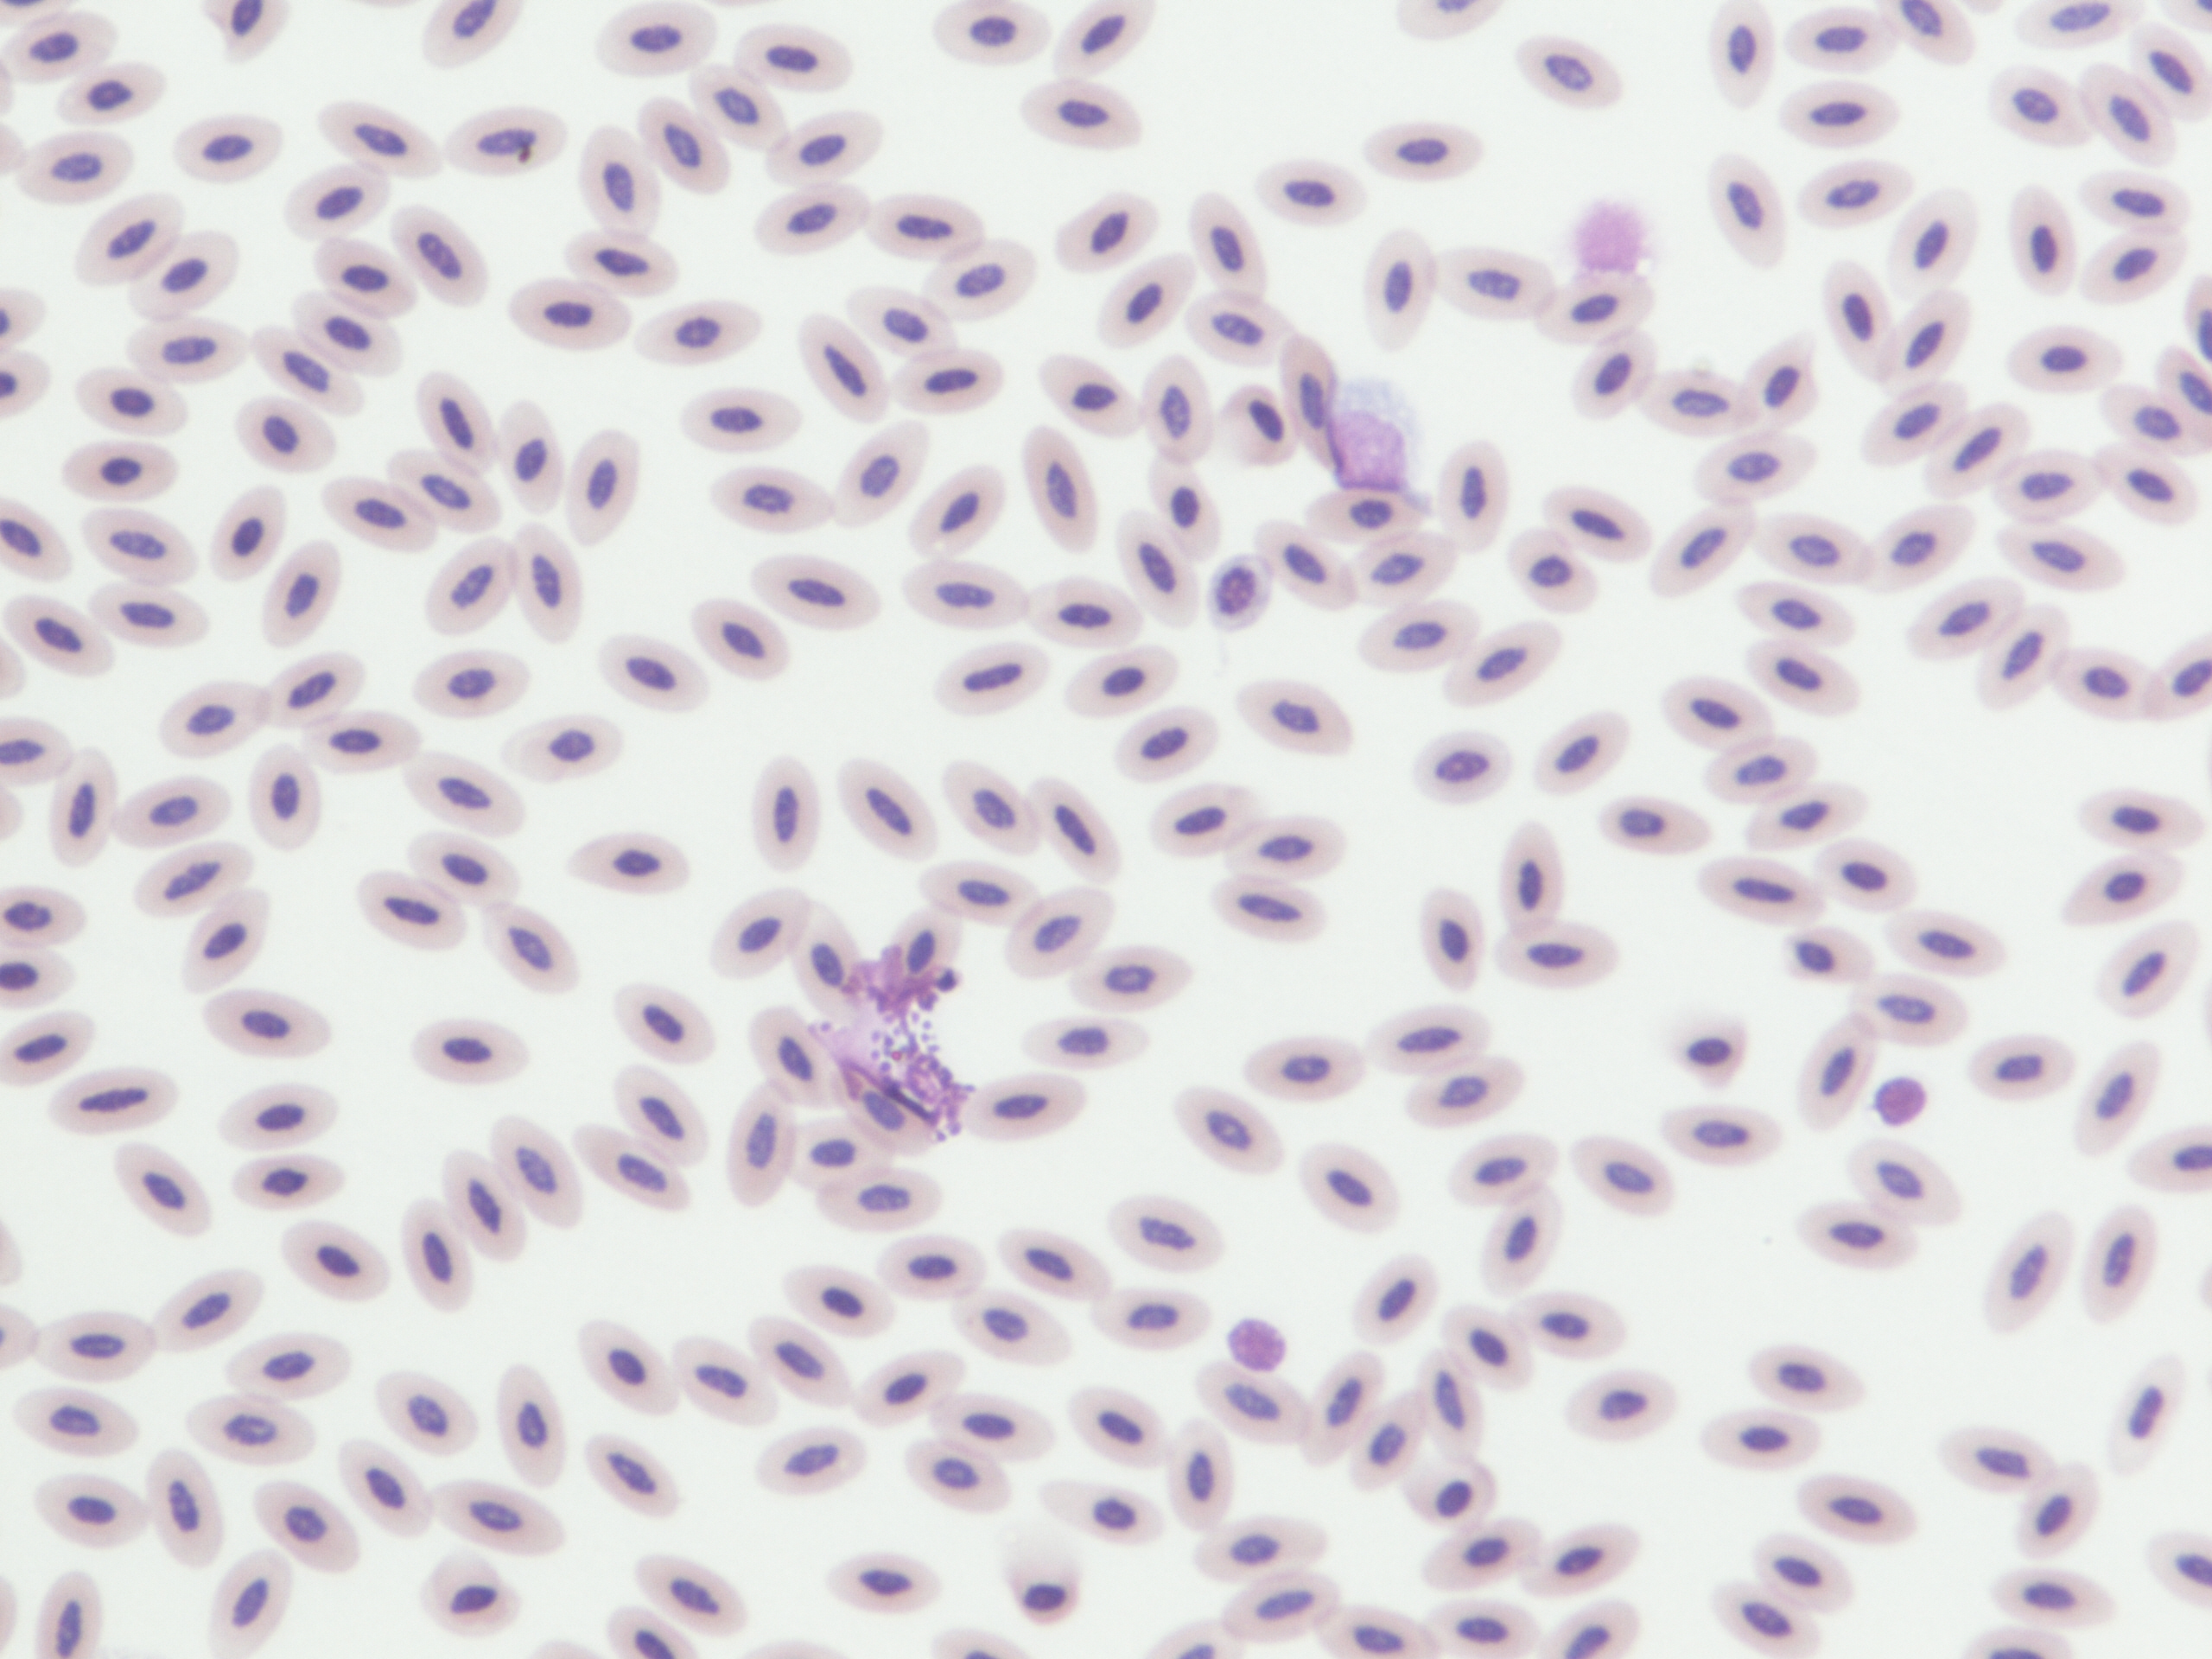

Tytuł:
Wzrost konkurencyjności spółki na rynku drobiarskim poprzez wdrożenie innowacyjnej organizacji produkcji, marketingu oraz technologii lęgu piskląt indyków.
Działanie WSPÓŁPRACA objęte Programem Rozwoju Obszarów Wiejskich na lata 2014–2020
[więcej]

Wzrost konkurencyjności spółki na rynku drobiarskim
poprzez wdrożenie innowacyjnej organizacji
Zakłada się, że realizacja założeń projektu przyczyni się do:
- Zapobiegania lub zmniejszenia wylęgu piskląt o zróżnicowanych parametrach fizjologicznych (masa ciała) z tej samej partii jaj wylęgowych,
- Eliminację jaj wylęgowych z zaburzeniami embriogenezy, co wiąże się z ograniczeniem uśmiercania piskląt po wylęgu,
- Analizę porównawczą odsetka zamieralności zarodków w odniesieniu do płci w innowacyjnej i tradycyjnej technice lęgu,
- Poprawy warunków dobrostanu w następstwie ograniczania oddziaływania środowiskowych czynników stresowych oraz eliminacji zabiegów manipulacyjnych w czasie rozwoju embrionalnego,
- Poprawy jakości piskląt po wylęgu jako następstwo ograniczenia stresu, poprawy wskaźników immunologicznych i zdrowotnych,

Partnerzy projektu
Projekt realizowany przy współudziale kilku podmiotów:
- Lider:
ALGAMA S.A. - Jednostka naukowa:
Uniwersytet Przyrodniczy w Lublinie - Weterynarz:
AvianVet Maciej Ratkowski - Firma doradcza:
Uni-Ekspert Doradztwo Gospodarcze Zenon Andrzej Kucab

.jpeg)
.jpeg)
